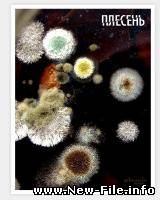
Плесень  СКАЧАТЬ БЕСПЛАТНО !!! Документальный фильм, 2008. HD КАЧЕСТВО!!!

| |  |
| |
В категории материалов: 98
Показано материалов: 51-98 |
Страницы: « 1 2 |
Сортировать по:
Дате ·
Названию ·
Рейтингу ·
Комментариям ·
Загрузкам ·
Просмотрам

|
Мега взрывы - Документальные съемки ядерных испытаний
Раздел: Документальное
Просмотров: 561
Скачиваний: 154
Добавил: ag555
|

|
Пикантные засветы участниц фабрики звезд.
Раздел: Документальное
Просмотров: 1562
Скачиваний: 242
Добавил: OVel
|

|
Сентябрьский номер / The september issue (2009) DVDRip
Раздел: Документальное
Просмотров: 391
Скачиваний: 114
Добавил: meyram
|

|
Билл Гейтс: Как чудак изменил мир / Bill Gates: How a Geek Changed the World (2008) DVDRip
Раздел: Документальное
Просмотров: 350
Скачиваний: 134
Добавил: meyram
|

|
Нострадамус: 2012 / Nostradamus: 2012 ( DVDRip )
Раздел: Документальное
Просмотров: 353
Скачиваний: 114
Добавил: meyram
|

|
Исаев (2009) SATRip / 1 - 16 серии
Раздел: Документальное
Просмотров: 493
Скачиваний: 123
Добавил: CHIP111
|

|
Искусство поцелуев (2009) SATRip
Раздел: Документальное
Просмотров: 614
Скачиваний: 137
Добавил: meyram
|

|
Michael Jackson This is it / Майкл Джексон: Вот и все (2009) CAMRip 2009
Раздел: Документальное
Просмотров: 351
Скачиваний: 127
Добавил: meyram
|

|
Laskovi mai / Ласковый май 2009
Раздел: Документальное
Просмотров: 1146
Скачиваний: 188
Добавил: meyram
|

|
ЛЕТАЮЩИЕ ТАРЕЛКИ ТРЕТЬЕГО РЕЙХА (документальный фильм)
Раздел: Документальное
Просмотров: 1798
Скачиваний: 313
Добавил: llvllvllvll
|

|
РАЗМЕННАЯ МОНЕТА (тайны событий 11.09.2001 в Нью Йорке) ТАК ЧТО ЖЕ НА САМОМ ДЕЛЕ ПРОИЗОШЛО В ТОТ ДЕНЬ???
Раздел: Документальное
Просмотров: 372
Скачиваний: 156
Добавил: llvllvllvll
|

|
Арнольд Шварценеггер: Ранние Годы / Arnold Schwarzenegger - The Early Years
Раздел: Документальное
Просмотров: 1199
Скачиваний: 135
Добавил: demonxp
|

|
Деформация времени Сезон 1 (20 Серий) / Time Warp (2008) HDTV 720p
Раздел: Документальное
Просмотров: 518
Скачиваний: 124
Добавил: Asmadey
|

|
Metal: A Headbanger's Journey(Путешествие металлиста)
Раздел: Документальное
Просмотров: 357
Скачиваний: 130
Добавил: dmit
|

|
Пепел и снег / Ashes and snow (2005) DVDRip
Раздел: Документальное
Просмотров: 602
Скачиваний: 125
Добавил: Gran
|

|
Тайная жизнь Чернобыля. Чистосердечное признание. Скачать
Раздел: Документальное
Просмотров: 502
Скачиваний: 131
Добавил: desti
|

|
Тюнинг как стиль жизни!!!!!!!!!!!!Смотрим все.Фильм про тюнинг...
Раздел: Документальное
Просмотров: 1453
Скачиваний: 201
Добавил: aston89
|

|
Зона криминала - Коронованные воры 2 (1-9 из 9) (2008) DVDRip
Раздел: Документальное
Просмотров: 1059
Скачиваний: 134
Добавил: graf_bazarov
|

|
Деньги пирамида долгов- Money As Debt
Раздел: Документальное
Просмотров: 675
Скачиваний: 148
Добавил: MrAlex
|

|
Как размножаются деньги
Раздел: Документальное
Просмотров: 578
Скачиваний: 153
Добавил: MrAlex
Рейтинг: 5.0
|
|
Плесень СКАЧАТЬ БЕСПЛАТНО !!! Документальный фильм, 2008. HD КАЧЕСТВО!!!
Раздел: Документальное
Просмотров: 1140
Скачиваний: 328
Добавил: MrAlex
Рейтинг: 5.0
|

|
Эротический массаж / Erotic massage - Обучающий видео-курс. Скачать БЕСПЛАТНО.
Раздел: Документальное
Просмотров: 1024
Скачиваний: 291
Добавил: Dem13
Рейтинг: 5.0
|

|
Поцелуй - обучающий ролик, как правильно и сексуально научиться целоваться. Скачать БЕСПЛАТНО.
Раздел: Документальное
Просмотров: 750
Скачиваний: 268
Добавил: Dem13
Рейтинг: 4.0
Комментарии - 1
|

|
Ранетки Фильм о фильме (как снимали сериал)
Раздел: Документальное
Просмотров: 2097
Скачиваний: 342
Добавил: Lerasteam
|

|
Яна Рудковская - Вечер С Тиграном Кеосаяном - О Разводе с Батуриным. СКАЧАТЬ
Раздел: Документальное
Просмотров: 497
Скачиваний: 170
Добавил: zaur
|

|
Чудо! Не понятно что это! СКАЧАТЬ
Раздел: Документальное
Просмотров: 472
Скачиваний: 169
Добавил: zaur
|

|
Московское метро .Ночная жизнь. Фильм СКАЧАТЬ
Раздел: Документальное
Просмотров: 506
Скачиваний: 211
Добавил: zaur
|

|
ЖИРИНОВСКИЙ - СЛОВО ПРАВДЫ .СКАЧАТЬ
Раздел: Документальное
Просмотров: 456
Скачиваний: 202
Добавил: zaur
|

|
Первый надводный ядерный взрыв
Раздел: Документальное
Просмотров: 488
Скачиваний: 227
Добавил: Elbert
|

|
Первая советская ядерная бомба
Раздел: Документальное
Просмотров: 480
Скачиваний: 195
Добавил: Elbert
|

|
Смертельный улов: Проверка боем
Раздел: Документальное
Просмотров: 728
Скачиваний: 218
Добавил: Bandos
|

|
Секретные истории. Эдгар Кейси. Нострадамус ХХ века
Раздел: Документальное
Просмотров: 518
Скачиваний: 211
Добавил: Bandos
|
| |
 | |  |
|
|





